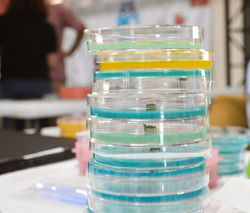
Mars-23.jpg

TRANSFORMAMOS AULAS
EN LABORATORIOS

EDUCACIÓN PARA EL FUTURO
Cambiando el mundo
En Rosalind creemos que al involucrar a jóvenes en talleres experimentales, podemos despertar un interés temprano en áreas de la ciencia, la tecnología y la ingeniería. Con ello, incrementaremos el número de profesionales en dichas áreas, y transformaremos nuestra sociedad en una basada en el conocimiento y la innovación.

PRODUCTOS Y SERVICIOS
LET´S MAKE INNOVATION
Curso virtual para el desarrollo de ideas de negocios de base científica y tecnológica. Este curso es perfecto para estudiantes de primaria y secundaria. Durante 8 semanas, los grupos de emprendedores se enfrentarán a diversos retos para resolver problemas con ideas innovadoras y validadas.
Contactenos para cotizar un grupo en su institución o empresa.




"La ciencia y la vida diaria no pueden, ni deben ser separadas"
Rosalind Franklin
LO MÁS NUEVO
Noticias y eventos
CIENCIA CON ASOCIACIÓN
EDUNÁMICA
La asociación Edunámica hace un trabajo increíble identificando estudiantes talentosos, y pudimos confirmarlo con el taller de microscopio y la extracción de ADN que realizamos. Durante 2020 desarrollamos un club científico virtual usando el más novedoso kit científico de Rosalind Innovations.
PODCAST
CAFÉ 1820
Tuvimos la oportunidad de grabar un podcast para la campaña #YoSoyElCafé de café 1820 con Jorge Vindas. Escuchalo en el link.
FERIA CIENTÍFICA COLEGIO METODISTA
Pudimos ser parte de la feria científica de esta institución tan especial. La experiencia Rosalind estuvo cerca de todos y todas los estudiantes de la institución.
HACIENDO CIENCIA EN GRECIA
Nos fuimos para el C.T.P. Bolivar en Grecia a dar un taller introductorio de microbiología. Fue una experiencia súper bonita y esperamos volver con todos los científicos en potencia que conocimos. Video resumen de nuestra experiencia.